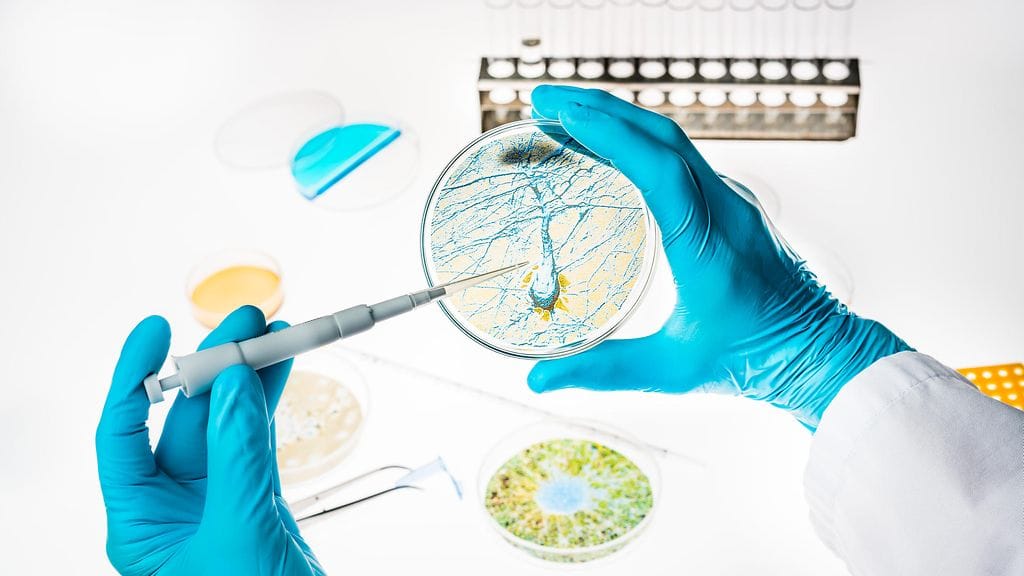

Japani aikoo sallia ihmiselinten kasvattamisen eläinten sisällä. Hallituksen odotetaan hyväksyvän perustutkimuksen aloittamisen aikaisintaan huhtikuussa. Asiasta kertoo The Japan Times.
Tällä hetkellä Japani sallii kantasolujen pistämisen hedelmöittyneisiin eläinten munasoluihin. Nyt asiantuntijapaneeli sallisi näin syntyneiden alkioiden istuttamisen eläimen kohtuun ja menetelmällä syntyvän jälkeläisen hyödyntämisen.
Asiantuntijat harkitsevat sikojen käyttöä kokeisiin, sillä niiden sisäelinten koot ovat lähellä ihmisen vastaavia. Asiantuntijaraportin mukaan tutkimukselle olisi kuitenkin asetettava tiukat valvontajärjestelmät.